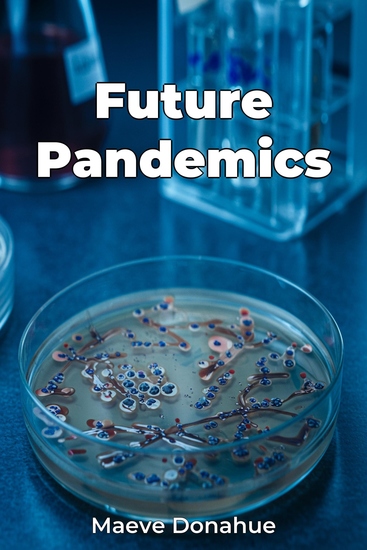

Future Pandemics
Maeve Donahue
Traducteur A AI
Maison d'édition: Publifye
Synopsis
Future Pandemics addresses the crucial question of global readiness for future health crises, highlighting vulnerabilities exposed by COVID-19. It argues for a proactive, multifaceted approach encompassing scientific innovation, international collaboration, and robust public health infrastructure. The book emphasizes the necessity of enhanced disease surveillance, noting how delays in detecting emerging pathogens during COVID-19 underscored the need for early warning systems. It also explores the importance of investing in research and development for vaccines and therapeutics. The rapid development of COVID-19 vaccines showcased scientific potential, while revealing gaps in addressing variants. The book analyzes the vital role of public health infrastructure, including healthcare capacity and equitable access to services, citing disparities during COVID-19 as a critical concern. Examining historical pandemics and the evolution of global health security frameworks provides essential context. The book progresses logically, beginning with key concepts of pandemic preparedness and delving into lessons from COVID-19. Subsequent sections focus on strengthening global surveillance, accelerating research, and enhancing public health infrastructure, culminating in practical strategies and policy recommendations for preventing future pandemics.














